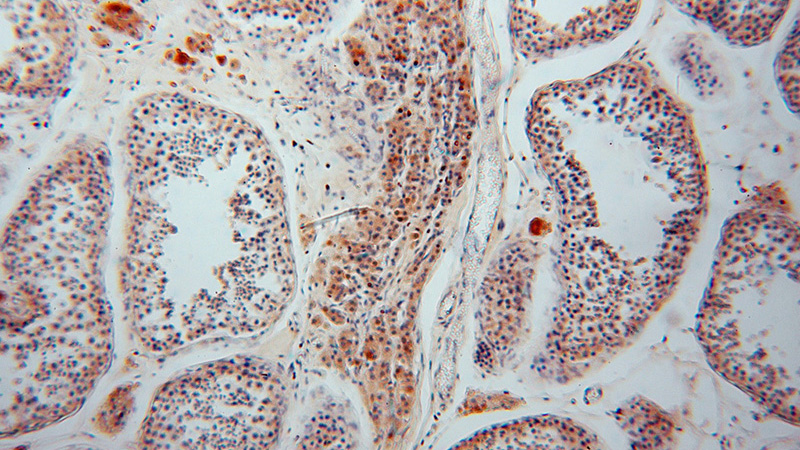
Immunohistochemical of paraffin-embedded human testis using Catalog No:113789(PGM1 antibody) at dilution of 1:100 (under 10x lens)

-
Product Name
PGM1 antibody
- Documents
-
Description
PGM1 Rabbit Polyclonal antibody. Positive FC detected in HepG2 cells. Positive IHC detected in human testis tissue, human hepat℃irrhosis tissue. Positive IF detected in HepG2 cells. Positive WB detected in mouse heart tissue, HEK-293 cells, HeLa cells, Jurkat cells, mouse skin tissue. Positive IP detected in mouse skin tissue. Observed molecular weight by Western-blot: 61 kDa
-
Tested applications
ELISA, WB, IHC, IF, FC, IP
-
Species reactivity
Human,Mouse,Rat; other species not tested.
-
Alternative names
Glucose phosphomutase 1 antibody; PGM 1 antibody; PGM1 antibody; phosphoglucomutase 1 antibody
-
Isotype
Rabbit IgG
-
Preparation
This antibody was obtained by immunization of PGM1 recombinant protein (Accession Number: NM_002633). Purification method: Antigen affinity purified.
-
Clonality
Polyclonal
-
Formulation
PBS with 0.02% sodium azide and 50% glycerol pH 7.3.
-
Storage instructions
Store at -20℃. DO NOT ALIQUOT
-
Applications
Recommended Dilution:
WB: 1:500-1:5000
IP: 1:500-1:5000
IHC: 1:20-1:200
IF: 1:20-1:200
-
Validations

mouse heart tissue were subjected to SDS PAGE followed by western blot with Catalog No:113789(PGM1 antibody) at dilution of 1:1000
Immunohistochemical of paraffin-embedded human testis using Catalog No:113789(PGM1 antibody) at dilution of 1:100 (under 10x lens)

Immunohistochemical of paraffin-embedded human testis using Catalog No:113789(PGM1 antibody) at dilution of 1:100 (under 40x lens)

Immunofluorescent analysis of HepG2 cells, using PGM1 antibody Catalog No:113789 at 1:25 dilution and Rhodamine-labeled goat anti-rabbit IgG (red).

IP Result of anti-PGM1 (IP:Catalog No:113789, 4ug; Detection:Catalog No:113789 1:1000) with mouse skin tissue lysate 3200ug.

1X10^6 HepG2 cells were stained with 0.2ug PGM1 antibody (Catalog No:113789, red) and control antibody (blue). Fixed with 90% MeOH blocked with 3% BSA (30 min). Alexa Fluor 488-congugated AffiniPure Goat Anti-Rabbit IgG(H+L) with dilution 1:1500.
-
Background
PGM1(Phosphoglucomutase-1) is also named as glucose phosphomutase 1 and belongs to the phosphohexose mutase family. It catalyzes the transfer of phosphate between the 1 and 6 positions of glucose. In most cell types, PGM1 isozymes predominate, representing about 90% of total PGM activity. One exception is red cells, where PGM2 is a major isozyme(PMID:8257433). Defects in PGM1 are the cause of glycogen storage disease type 14 (GSD14)(PMID:19625727). It has 2 isoforms produced by alternative splicing.
-
References
- Pérez B, Medrano C, Ecay MJ. A novel congenital disorder of glycosylation type without central nervous system involvement caused by mutations in the phosphoglucomutase 1 gene. Journal of inherited metabolic disease. 36(3):535-42. 2013.
Related Products / Services
Please note: All products are "FOR RESEARCH USE ONLY AND ARE NOT INTENDED FOR DIAGNOSTIC OR THERAPEUTIC USE"
